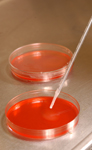

K-STATE TAKES PART IN RECYCLEMANIA
|
K-STATE TO HEAD THE NATIONAL CENTER OF EXCELLENCE FOR EMERGING AND ZOONOTIC ANIMAL DISEASES
K-State's expertise in vaccine development, diagnostics, animal disease detection and education programs formed the basis for the university's selection as a Center of Excellence for Emerging and Zoonotic Animal Diseases by the Department of Homeland Security, said K-State President Kirk Schulz. K-State will receive $12 million over the next six years.
K-State's expertise in vaccine development, diagnostics, animal disease detection and education programs formed the basis for the university's selection as a Center of Excellence for Emerging and Zoonotic Animal Diseases by the Department of Homeland Security, said K-State President Kirk Schulz. K-State will receive $12 million over the next six years.
K-State will partner with Texas A&M University's Foreign Animal and Zoonotic Disease Defense Center to co-lead the Science and Technology Directorate's efforts to involve university researchers in zoonotic and animal disease detection.
Juergen Richt, a Regents Distinguished Professor in K-State's College of Veterinary Medicine, is principal investigator and the center's director.
PICTURE PERFECT |
OH, BY THE WAY
OPEN FORUMS ABOUT NEW ZIMBRA CALENDAR TO BEGIN
Beginning March 5, K-State's information technology services will host a series of open forums to provide information about and demonstrate the new K-State Zimbra Calendar.
Read more
POET CURTIS CRISLER TO GIVE READING FOR K-STATE'S CHILDREN'S LIT CONFERENCE MARCH 6
Poet Curtis Crisler will read from his work and act as keynote speaker for K-State's upcoming conference on children's literature.
Read more
YALE EXPERT ON GLOBAL POVERTY AND JUSTICE TO PRESENT UNIVERSITY DISTINGUISHED LECTURE AT K-STATE MARCH 8
Thomas Pogge, a professor of philosophy and international affairs at Yale University, will present "Human Rights and Global Justice" at 6:30 p.m. Monday, March 8, at the K-State Alumni Center.
The lecture is part of the University Distinguished Lecture Series and is free and open to the public.
Read more
OPPORTUNITIES CLASSIFIED • A recording of classified job opportunities is available 24 hours a day on the Employment Information Line, 785-532-6271. • A list of employment opportunities is posted at www.k-state.edu/hr/ • For additional information, call 785-532-6277 or come to the Division of Human Resources in 103 Edwards Hall. Applications are accepted 8 a.m. - 5 p.m. weekdays. UNCLASSIFIED • A complete listing of vacancies can be seen at www.k-state.edu/affact/ • For additional information, call the office of affirmative action at 785-532-6220 or come by 214 Anderson Hall. |
Editor: Katie Mayes
Coordinator: Julie Fosberg
Phone: 785-532-6415
Fax: 785-532-6418
E-mail: media@k-state.edu
 For the second year, K-State is competing in the 10-week national Recyclemania program, a friendly competition among colleges and universities that aims to promote recycling on campus.
For the second year, K-State is competing in the 10-week national Recyclemania program, a friendly competition among colleges and universities that aims to promote recycling on campus.  Joe Aistrup, political science, and colleague published "Kansas Politics and Government: The Clash of Political Cultures," University of Nebraska Press, March 2010.
Joe Aistrup, political science, and colleague published "Kansas Politics and Government: The Clash of Political Cultures," University of Nebraska Press, March 2010. 
